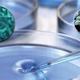
Micr

-
Destaco el origen de las enfermedades y emitió el criterio de que las enfermedades eran producidas por miasmas
-
Dio la hipótesis de la sífilis producida por un agente vivo imperceptible para nuestros sentidos, escribió un libro llamado" de contagion encontagiosis morvis"
-
Gracias a un microscopio demostró la existencia estos diminutos agentes en la saliva como en el agua, materia orgánica descompuesta, heces humanas y sarro en los dientes
-
Sostenía que los microorganismos podrían surgir de forma espontanea en un caldo nutritivo
-
Repitió los experimentos de needham y sugirió que los resultados se debían al ingreso de microorganismos
-
introdujo la vacunación contra la viruela empleando los virus de la postulo-sis vacuna
-
fue el primero en observar bacterias en los tejidos durante la infección como el carbunco y demostró un aumento de virulencia en el paso de los animales
-
demostró que los diferentes tipos de bacterias tenían actividades biologícas y necesidades de cultivos diferentes, demostró que algunos microbios pueden crecer sin oxigeno
-
pretendiendo defender la teoría de la generación espontanea sostuvo que el calentamiento expulsaba el aire y era un factor fundamental en la generación espontanea
-
observo la microbacterias en leprae en los tejidos de leprosos fue la primera ves que se observaron bacterias en las lesiones humanas
-
introdujo un buen resultado en los métodos para teñir las bacterias empleando colorante anilina
-
observo el ciclo de la esporulación de bacilos y demostró en forma concluyente que era la carsa especifica del carbunco, introdujo el método de cultivo puro y descubrió el bacilo tuberculoso
-
demostró en forma concluyente que los microbios acompañan a partículas de polvo en el aire y que son de tipo termo la vila y termo estable.
lister introdujo la practica de cirugía antiséptica obtuvo los primeros cultivos puros de bacterias -
Gram desrrollo el método de tincion de gram. Élie Metchnikoff. introdujo el concepto que la inmunidad celular antimicrobiana es realizada por los fagocitos.
-
introdujeron el uso de vacunas muertas
-
demostraron que la toxina bacteriana puede explicar la actividad patogena de un organismo
-
descubrió los anticuerpos la antitoxina y differico
-
estableció que los anticuerpos y la lexina pueden lisar ciertas bacterias y células de mamíferos
-
introdujo el diagnostico especifico de enfermedad infecciosa como prueba de widal para la fiebre tifoidea
-
descubrió la causa de la fiebre manchada de las montañas rocosas Rickettsia rickettsii
-
introdujo el método para estandarizar toxinas y antitoxinas con el método de definición, introdujo la quimioterapia y gano el premio nobel
-
descubrió la función de simasa de levadura en las enfermedades alcohólicas
-
introdujo la cuti reacción con toxina differia, para medir la inmunidad ala differia
-
descubrió el agente bacteriológico lisozima descubrió la penicilina antibiótico mas usado en la quimioterapia
-
Introdujo el principio de convertir la toxina de un agente inmunizante no toxico el toxoide
-
¿ Se podría purificar el agua con una maquina echa a base de recursos reciclables ?
A list shows items. A timeline shows sequence.
Use Timetoast to make dates, milestones, and turning points easier to understand in a clear visual format. Timetoast is a timeline maker for work, school, research, and stories.